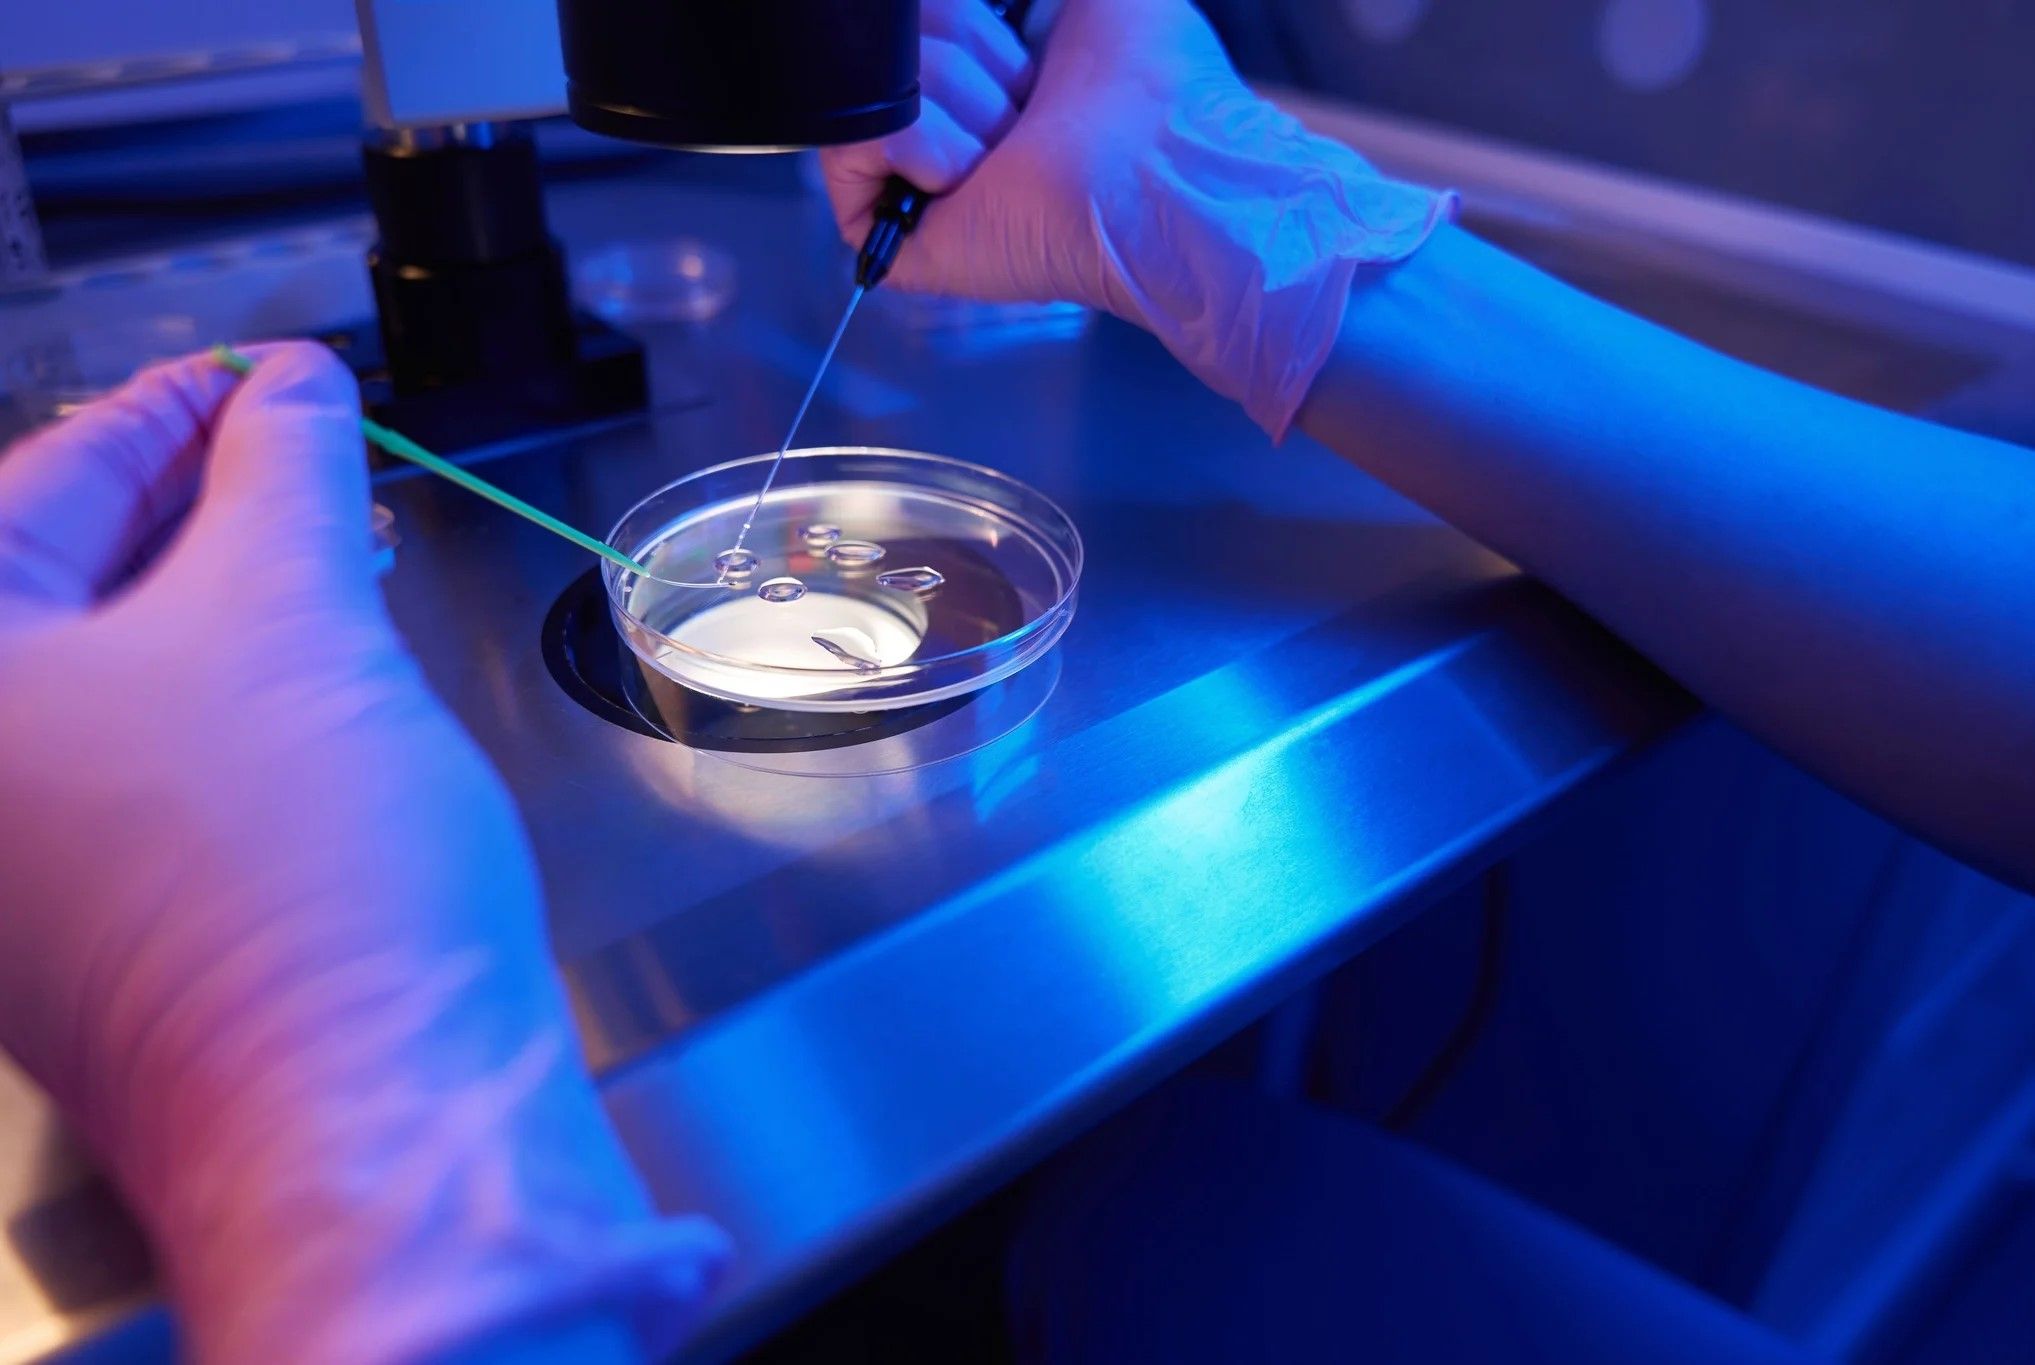

Oftringen
Oftringen ehrt seinen Weltklasse-Turner: Noe Seifert offiziell von der Gemeinde empfangen
Vergangene Woche wurde Noe Seifert in der Mehrzweckhalle in Oftringen geehrt. Seine Bronzemedaille ist die erste Schweizer WM-Auszeichnung in dieser Disziplin seit 75 Jahren. Ein Meilenstein, der Oftringen für einen Abend zum Mittelpunkt der Turnwelt machte.

Abstimmung
Eine Viertelmillion für die Dienstpflicht von Frauen: Kämpfer gegen «Männerbenachteiligung» öffnet sein Portemonnaie

Verkehr
Drängelnde Töffs, nervende Lastenvelos, PS-Monster für Junglenker – doch der Bundesrat will keine neuen Gesetze

Öffentlicher Verkehr
Aargauer SVP-Nationalrat kritisiert den Vergabeentscheid der SBB – und sorgt sich um «ökologischen Fussabdruck»

Strafbefehl
Aargauer Bauern liefen innert fünf Tagen siebenmal die Geissen davon – jetzt muss er dafür zahlen

Aarau
«Dazu ist der Wohnraum in Aarau viel zu knapp»: Wie dieser Hausbesitzer das Ausziehen attraktiv machen will

Baden
Sie rief den «Winterzauber» auf dem Bahnhofplatz ins Leben – wie diese Grafikerin die Stadt seit 30 Jahren prägt

Region
Dank Aarburg und Strengelbach qualifiziert sich der Wirtschaftsraum Zofingen für Unterstützung durch den Kanton

Wolfwil
«Da kann man am Samstag auch mal die Sau rauslassen»: Wolfwil und der Gemeindepräsident im Bann der grossen Technoparty

Abstimmung
Erbschaftssteuer-Initiative: Milliardär Willy Michel würde auswandern – er weiss schon, wohin

Rothrist
Schokokuss-Schleuder und Sockenmonster: Blick hinter die Kulissen der Arbeits- und Wohngemeinschaft Borna

Energie
Axpo erhält ein neues Vergütungssystem – doch der Lohndeckel für den CEO sitzt ziemlich locker

FC Aarau
Der Goalie hält keinen Ball, ein Verteidiger patzt gleich dreifach: Die FCA-Noten zum 1:5 in Bellinzona

Landwirtschaft
«Trump hat das Milchglas zum Überlaufen gebracht» – führende US-Zeitung schreibt über unübliche Kuhschlachtungen in der Schweiz

Aargau
Aargauer Linke kritisieren drohenden 90-Millionen-Sparhammer von SVP und FDP – das fordern sie

Interview
Konrad Liechti vor der Vizeammanwahl: «Ich bin einer, der mit dem Ammann auf Augenhöhe arbeiten kann»

Fussball
Zaubermaus Ratinho kehrt für ein Spiel in die Schweiz zurück: «Das Spiel mit Ronaldinho wird etwas ganz Besonderes»

Automobil
Crashende Tesla-Verkäufe: Hätte Elon Musk besser auf Basketball-Star Michael Jordan gehört?

Interview
Krach um milliardenschwere Bucherer-Stiftung – jetzt spricht Präsident Urs Mühlebach: «Das war mein Fehler»

Analyse
Bundesrat übernimmt EU-Regel fürs Töff-Fahren – jetzt gibt es mehr Tote: Was die Lehre daraus ist